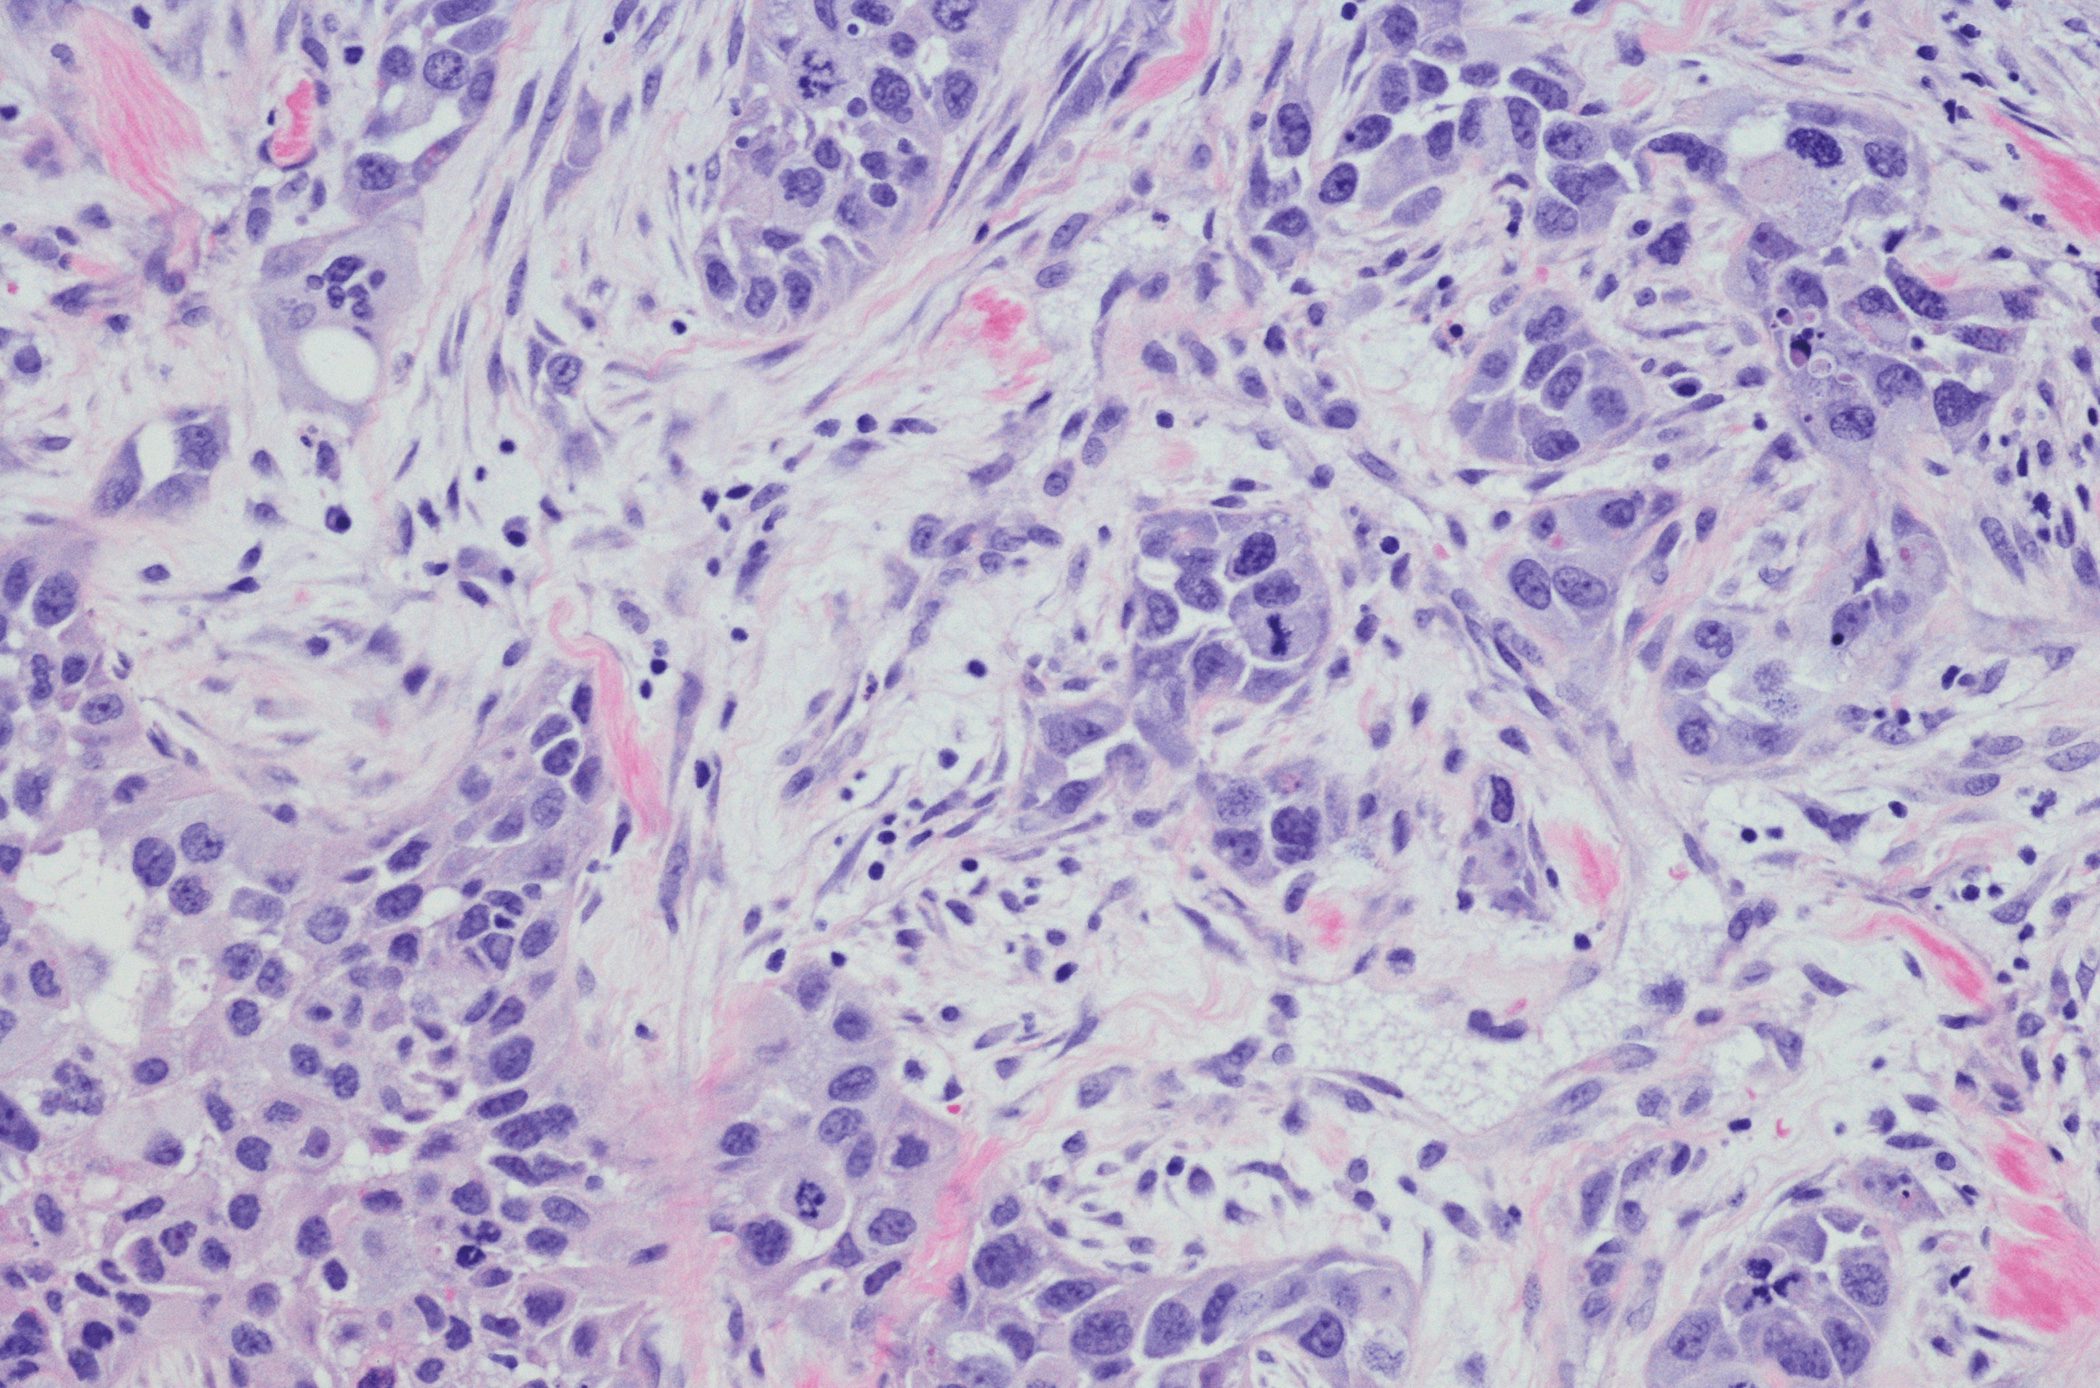

A prevalência de urticária ao longo da vida é de quase 20%. Os anti-histamínicos de segunda geração são também recomendados como tratamento de primeira escolha para os doentes pediátricos. No entanto, os doentes pediátricos com pápulas pruriginosas nem sempre sofrem de uma forma (clássica) de urticária, como mostram claramente os relatórios do hospital pediátrico e a literatura especializada.
Autoren
- Mirjam Peter, M.Sc.
Publikation
- DERMATOLOGIE PRAXIS
Related Topics
You May Also Like
- Estudo pré-clínico de um agente fitoterapêutico
Ingrediente ativo combinação de óleo de hortelã-pimenta e cominho modificou o microbiota fecal
- Casuística
Rituximab utilizado eficazmente contra a colite IgG4-RD
- Sarcoidose
Novas opções, de JAKi a mTOR
- Carcinoma de células escamosas da cabeça e do pescoço
Imunoterapia de precisão e tratamento local
- Do sintoma ao diagnóstico
Dor abdominal – Quistos da próstata
- Terapia multimodal da doença de Parkinson
Efeitos positivos de uma intervenção baseada na música
- Psicofoncologia
A comunicação como chave para a adesão à terapêutica
- Cardiologia